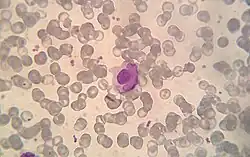

Antinuclear antibody


Antinuclear antibodies (ANAs, also known as antinuclear factor or ANF)[2] are autoantibodies that bind to contents of the cell nucleus. In normal individuals, the immune system produces antibodies to foreign proteins (antigens) but not to human proteins (autoantigens). In some cases, antibodies to human antigens are produced; these are known as autoantibodies.[3]
There are many subtypes of ANAs such as anti-Ro antibodies, anti-La antibodies, anti-Sm antibodies, anti-nRNP antibodies, anti-Scl-70 antibodies, anti-dsDNA antibodies, anti-histone antibodies, antibodies to nuclear pore complexes, anti-centromere antibodies and anti-sp100 antibodies. Each of these antibody subtypes binds to different proteins or protein complexes within the nucleus. They are found in many disorders including autoimmunity, cancer and infection, with different prevalences of antibodies depending on the condition. This allows the use of ANAs in the diagnosis of some autoimmune disorders, including systemic lupus erythematosus, Sjögren syndrome,[4] scleroderma,[5] mixed connective tissue disease,[6] polymyositis, dermatomyositis, autoimmune hepatitis[7] and drug-induced lupus.[8]
The ANA test detects the autoantibodies present in an individual's blood serum. The common tests used for detecting and quantifying ANAs are indirect immunofluorescence and enzyme-linked immunosorbent assay (ELISA). In immunofluorescence, the level of autoantibodies is reported as a titre. This is the highest dilution of the serum at which autoantibodies are still detectable. Positive autoantibody titres at a dilution equal to or greater than 1:160 are usually considered as clinically significant. Positive titres of less than 1:160 are present in up to 20% of the healthy population, especially the elderly. Although positive titres of 1:160 or higher are strongly associated with autoimmune disorders, they are also found in 5% of healthy individuals.[9][10] Autoantibody screening is useful in the diagnosis of autoimmune disorders and monitoring levels helps to predict the progression of disease.[8][11][12] A positive ANA test is seldom useful if other clinical or laboratory data supporting a diagnosis are not present.[13]
Immunity and autoimmunity
The human body has many defense mechanisms against pathogens, one of which is humoral immunity. This defence mechanism produces antibodies (large glycoproteins) in response to an immune stimulus. Many cells of the immune system are required for this process, including lymphocytes (T-cells and B-cells) and antigen presenting cells. These cells coordinate an immune response upon the detection of foreign proteins (antigens), producing antibodies that bind to these antigens. In normal physiology, lymphocytes that recognise human proteins (autoantigens) either undergo programmed cell death (apoptosis) or become non-functional. This self-tolerance means that lymphocytes should not incite an immune response against human cellular antigens. Sometimes, however, this process malfunctions and antibodies are produced against human antigens, which may lead to autoimmune disease.[3]
ANA subtypes
ANAs are found in many disorders, as well as some healthy individuals. These disorders include: systemic lupus erythematosus (SLE), rheumatoid arthritis, Sjögren syndrome, scleroderma, polymyositis, dermatomyositis, primary biliary cirrhosis, drug induced lupus, autoimmune hepatitis, multiple sclerosis, discoid lupus, thyroid disease, antiphospholipid syndrome, juvenile idiopathic arthritis, psoriatic arthritis, juvenile dermatomyositis, idiopathic thrombocytopaenic purpura, infection and cancer. These antibodies can be subdivided according to their specificity, and each subset has different propensities for specific disorders.[8][14]
Extractable nuclear antigens
Extractable nuclear antigens (ENA) are a group of autoantigens that were originally identified as antibody targets in people with autoimmune disorders. They are termed ENA because they can be extracted from the cell nucleus with saline.[8][15] The ENAs consist of ribonucleoproteins and non-histone proteins, named by either the name of the donor who provided the prototype serum (Sm, Ro, La, Jo), or the name of the disease setting in which the antibodies were found (SS-A, SS-B, Scl-70).[16]
Anti-Ro/SS-A and anti-La/SS-B

Anti-Ro and anti-La antibodies, also known as SS-A and SS-B, respectively, are commonly found in primary Sjögren's syndrome, an autoimmune disorder that affects the exocrine glands. The presence of both antibodies is found in 30–60% of Sjögren's syndrome, anti-Ro antibodies alone are found in 50–70% of Sjögren's syndrome and 30% of SLE with cutaneous involvement, and anti-La antibodies are rarely found in isolation.[11][17] Anti-La antibodies are also found in SLE; however, Sjögren's syndrome is normally also present.[18] Anti-Ro antibodies are also found less frequently in other disorders including autoimmune liver diseases, coeliac disease, autoimmune rheumatic diseases, cardiac neonatal lupus erythematosus and polymyositis.[19][20] During pregnancy, anti-Ro antibodies can cross the placenta and cause heart block[21][22] and neonatal lupus in babies.[23] In Sjögren's syndrome, anti-Ro and anti-La antibodies correlate with early onset, increased disease duration, parotid gland enlargement, disease outside the glands and infiltration of glands by lymphocytes.[12] Anti-Ro antibodies are specific to components of the Ro-RNP complex, comprising 45kDa, 52kDa, 54kDa and 60kDa proteins and RNA. The 60kDa DNA/RNA binding protein and 52kDa T-cell regulatory protein are the best characterised antigens of anti-Ro antibodies. Collectively, these proteins are part of a ribonucleoprotein (RNP) complex that associate with the human Y RNAs, hY1-hY5. The La antigen is a 48kDa transcription termination factor of RNA polymerase III, which associates with the Ro-RNP complex.[16][17][24][25]
The mechanism of antibody production in Sjögren's syndrome is not fully understood, but apoptosis (programmed cell death) and molecular mimicry may play a role.[12] The Ro and La antigens are expressed on the surface of cells undergoing apoptosis and may cause the inflammation within the salivary gland by interaction with cells of the immune system. The antibodies may also be produced through molecular mimicry, where cross reactive antibodies bind to both virus and human proteins. This may occur with one of the antigens, Ro or La, and may subsequently produce antibodies to other proteins through a process known as epitope spreading. The retroviral gag protein shows similarity to the La protein and is proposed as a possible example for molecular mimicry in Sjögren's syndrome.[12][20]
Anti-Sm
Anti-Smith (Anti-Sm) antibodies are a very specific marker for SLE. Approximately 99% of individuals without SLE lack anti-Sm antibodies, but only 20% of people with SLE have the antibodies. They are associated with central nervous system involvement, kidney disease, lung fibrosis and pericarditis in SLE, but they are not associated with disease activity. The antigens of the anti-Sm antibodies are the core units of the small nuclear ribonucleoproteins (snRNPs), termed A to G, and will bind to the U1, U2, U4, U5 and U6 snRNPs. Most commonly, the antibodies are specific for the B, B' and D units.[26][27] Molecular and epidemiological studies suggest that anti-Sm antibodies may be induced by molecular mimicry because the protein shows some similarity to Epstein-Barr virus proteins.[28][29]
Anti-nRNP/anti-U1-RNP
Anti-nuclear ribonucleoprotein (anti-nRNP) antibodies, also known as anti-U1-RNP antibodies, are found in 30–40% of SLE. They are often found with anti-Sm antibodies, but they may be associated with different clinical associations. In addition to SLE, these antibodies are highly associated with mixed connective tissue disease. Anti-nRNP antibodies recognise the A and C core units of the snRNPs and because of this they primarily bind to the U1-snRNP.[26][30] The immune response to RNP may be caused by the presentation of the nuclear components on the cell membrane in apoptotic blebs. Molecular mimicry has also been suggested as a possible mechanism for the production of antibodies to these proteins because of similarity between U1-RNP polypeptides and Epstein-Barr virus polypeptides.[31]
Anti-Scl-70/anti-topoisomerase I
Anti-Scl-70 antibodies are linked to scleroderma.[32] The sensitivity of the antibodies for scleroderma is approximately 34%, but is higher for cases with diffuse cutaneous involvement (40%), and lower for limited cutaneous involvement (10%). The specificity of the antibodies is 98% and 99.6% in other rheumatic diseases and normal individuals, respectively.[8][33] In addition to scleroderma, these antibodies are found in approximately 5% of individuals with SLE.[34] The antigenic target of anti-Scl-70 antibodies is topoisomerase I.[35]
Anti-Jo-1
Although anti-Jo-1 antibodies are often included with ANAs, they are actually antibodies to the cytoplasmic protein, Histidyl-tRNA synthetase – an aminoacyl-tRNA synthetase essential for the synthesis of histidine loaded tRNA.[15] They are highly associated with polymyositis and dermatomyositis, and are rarely found in other connective tissue diseases. Around 20–40% of polymyositis is positive for Jo-1 antibodies and most will have interstitial lung disease, HLA-DR3 and HLA-DRw52 human leukocyte antigen (HLA) markers; collectively known as Jo-1 syndrome.[26][36]
Anti-dsDNA

Anti-double stranded DNA (anti-dsDNA) antibodies are highly associated with SLE. They are a very specific marker for the disease, with some studies quoting nearly 100%.[8] Data on sensitivity ranges from 25 to 85%. Anti-dsDNA antibody levels, known as titres, correlate with disease activity in SLE; high levels indicate more active lupus. The presence of anti-dsDNA antibodies is also linked with lupus nephritis and there is evidence they are the cause. Some anti-dsDNA antibodies are cross reactive with other antigens found on the glomerular basement membrane (GBM) of the kidney, such as heparan sulphate, collagen IV, fibronectin and laminin. Binding to these antigens within the kidney could cause inflammation and complement fixation, resulting in kidney damage. Presence of high DNA-binding and low C3 levels have been shown to have extremely high predictive value (94%) for the diagnosis of SLE.[37] It is also possible that the anti-dsDNA antibodies are internalised by cells when they bind membrane antigens and then are displayed on the cell surface. This could promote inflammatory responses by T-cells within the kidney. It is important to note that not all anti-dsDNA antibodies are associated with lupus nephritis and that other factors can cause this symptom in their absence. The antigen of anti-dsDNA antibodies is double stranded DNA.[38][39]
Anti-histone antibodies
Anti-histone antibodies are found in the serum of up to 75–95% of people with drug-induced lupus and 75% of idiopathic SLE. Unlike anti-dsDNA antibodies in SLE, these antibodies do not fix complement. Although they are most commonly found in drug induced lupus, they are also found in some cases of SLE, scleroderma, rheumatoid arthritis and undifferentiated connective tissue disease. Many drugs are known to cause drug induced lupus and they produce various antigenic targets within the nucleosome that are often cross reactive with several histone proteins and DNA. Procainamide causes a form of drug-induced lupus that produces antibodies to the histone H2A and H2B complex.[40][41]
Anti-gp210 and anti-p62
Both anti-glycoprotein-210 (anti-gp210) and anti-nucleoporin 62 (anti-p62) antibodies are antibodies to components of the nuclear membrane and are found in primary biliary cirrhosis (PBC). Each antibody is present in approximately 25–30% of PBC. The antigens of both antibodies are constituents of the nuclear membrane. gp210 is a 200kDa protein involved in anchoring components of the nuclear pore to the nuclear membrane. The p62 antigen is a 60kDa nuclear pore complex.[42][43]
Anti-centromere antibodies

Anti-centromere antibodies are associated with limited cutaneous systemic sclerosis, also known as CREST syndrome, primary biliary cirrhosis and proximal scleroderma.[44] There are six known antigens, which are all associated with the centromere; CENP-A to CENP-F. CENP-A is a 17kDa histone H3-like protein. CENP-B is an 80kDa DNA binding protein involved in the folding of heterochromatin. CENP-C is a 140kDa protein involved in kinetochore assembly. CENP-D is a 50kDa protein of unknown function, but may be homologous to another protein involved in chromatin condensation, RCC1. CENP-E is a 312kDa protein from the kinesin motor protein family. CENP-F is a 367kDa protein from the nuclear matrix that associates with the kinetochore in late G2 phase during mitosis. CENP-A, B and C antibodies are most commonly found (16–42% of systemic sclerosis) and are associated with Raynaud's phenomenon, telangiectasias, lung involvement and early onset in systemic sclerosis.[33][45][46]
Anti-centromere antibodies are found in approximately 60% of patients with limited systemic scleroderma and in 15% of those with the diffuse form of scleroderma. The specificity of this test is >98%. Thus, a positive anti-centromere antibody finding is strongly suggestive of limited systemic scleroderma. Anti-centromere antibodies present early in the course of disease and are notably predictive of limited cutaneous involvement and a decreased likelihood of aggressive internal organ involvement, such as fibrosis in the lungs.[47]
When present in primary biliary cirrhosis, ACAs are prognostic of portal hypertension such that serum ACA levels correlate with the severity of portal hypertension.[48]
Anti-sp100
Anti-sp100 antibodies are found in approximately 20–30% of primary biliary cirrhosis (PBC). They are found in few individuals without PBC, and therefore are a very specific marker of the disease. The sp100 antigen is found within nuclear bodies; large protein complexes in the nucleus that may have a role in cell growth and differentiation.[49]
Anti-PM-Scl
Anti-PM-Scl antibodies are found in up to 50% of polymyositis/systemic sclerosis (PM/SSc) overlap syndrome. Around 80% of individuals with antibodies present in their blood serum will have the disorder. The presence of the antibodies is linked to limited cutaneous involvement of PM/SSc overlap syndrome. The antigenic targets of the antibodies are components of the RNA-processing exosome complex in the nucleolus.[33] There are ten proteins in this complex and antibodies to eight of them are found at varying frequencies; PM/Scl-100 (70–80%), PM/Scl-75 (46–80%), hRrp4 (50%), hRrp42 (21%), hRrp46 (18%), hCs14 (14%), hRrp41 (10%) and hRrp40 (7%).[50]
Anti-DFS70 antibodies
Anti-DFS70 antibodies generate a dense fine speckled pattern in indirect immunofluorescence and are found in normals and in various conditions, but are not associated with a systemic autoimmune pathology. Therefore, they can be used to help to rule out such conditions in ANA positive individuals. A significant number of patients are diagnosed as systemic lupus erythematosus or undifferentiated connective tissue disease largely based on a positive ANA. In case no defined autoantibody can be detected (e.g. anti-ENA antibodies), the testing of anti-DFS70 antibodies is recommended to verify the diagnosis. Anti-DFS70 antibody tests are available as CE-marked tests. Until now, no FDA cleared assay is available.[51]
ANA test


The presence of ANAs in blood can be confirmed by a screening test. Although there are many tests for the detection of ANAs, the most common tests used for screening are indirect immunofluorescence and enzyme-linked immunosorbent assay (ELISA).[52] Following detection of ANAs, various subtypes are determined.[8]
Indirect immunofluorescence
Indirect immunofluorescence is one of the most commonly used tests for ANAs. Typically, HEp-2 cells are used as a substrate to detect the antibodies in human serum. Microscope slides are coated with HEp-2 cells and the serum is incubated with the cells. If the said and targeted antibodies are present then they will bind to the antigens on the cells; in the case of ANAs, the antibodies will bind to the nucleus. These can be visualised by adding a fluorescent tagged (usually FITC or rhodopsin B) anti-human antibody that binds to the antibodies. The molecule will fluoresce when a specific wavelength of light shines on it, which can be seen under the microscope. Depending on the antibody present in the human serum and the localisation of the antigen in the cell, distinct patterns of fluorescence will be seen on the HEp-2 cells.[53][54] Levels of antibodies are analysed by performing dilutions on blood serum. An ANA test is considered positive if fluorescence is seen at a titre of 1:40/1:80. Higher titres are more clinically significant as low positives (≤1:160) are found in up to 20% of healthy individuals, especially the elderly. Only around 5% of the healthy population have ANA titres of 1:160 or higher.[8][55]
HEp-2

Until around 1975, when HEp-2 cells were introduced, animal tissue was used as the standard substrate for immunofluorescence.[11] HEp-2 cells are currently one of the most common substrates for ANA detection by immunofluorescence.[56]
Originally started a laryngeal carcinoma strain, the cell line was contaminated and displaced by HeLa cells, and has now been identified as actually HeLa cells.[57]
They are superior to the previously used animal tissues because of their large size and the high rate of mitosis (cell division) in the cell line. This allows the detection of antibodies to mitosis-specific antigens, such as centromere antibodies. They also allow identification of anti-Ro antibodies, because acetone is used for fixation of the cells (other fixatives can wash the antigen away).[58]
There are many nuclear staining patterns seen on HEp-2 cells: homogeneous, speckled, nucleolar, nuclear membranous, centromeric, nuclear dot and pleomorphic. The homogeneous pattern is seen when the condensed chromosomes and interphase chromatin stain. This pattern is associated with anti-dsDNA antibodies, antibodies to nucleosomal components, and anti-histone antibodies. There are two speckled patterns: fine and coarse. The fine speckled pattern has fine nuclear staining with unstained metaphase chromatin, which is associated with anti-Ro and anti-La antibodies. The coarse staining pattern has coarse granular nuclear staining, caused by anti-U1-RNP and anti-Sm antibodies. The nucleolar staining pattern is associated with many antibodies including anti-Scl-70, anti-PM-Scl, anti-fibrillarin and anti-Th/To. Nuclear membrane staining appears as a fluorescent ring around the cell nucleus and are produced by anti-gp210 and anti-p62 antibodies. The centromere pattern shows multiple nuclear dots in interphase and mitotic cells, corresponding to the number of chromosomes in the cell. Nuclear dot patterns show between 13 and 25 nuclear dots in interphase cells and are produced by anti-sp100 antibodies. Pleomorphic pattern is caused by antibodies to the proliferating cell nuclear antigen.[26][55][59][60] Indirect immunofluorescence has been shown to be slightly superior compared to ELISA in detection of ANA from HEp-2 cells.[56]
Crithidia luciliae

Crithidia luciliae are haemoflaggelate single celled protists. They are used as a substrate in immunofluorescence for the detection of anti-dsDNA antibodies. They possess an organelle known as the kinetoplast which is a large mitochondrion with a network of interlocking circular dsDNA molecules. After incubation with serum containing anti-dsDNA antibodies and fluorescent-labelled anti-human antibodies, the kinetoplast will fluoresce. The lack of other nuclear antigens in this organelle means that using C. luciliae as a substrate allows for the specific detection of anti-dsDNA antibodies.[8][61][62]
ELISA
Enzyme-linked immunosorbent assay (ELISA) uses antigen-coated microtitre plates for the detection of ANAs.[63] Each well of a microtitre plate is coated with either a single antigen or multiple antigens to detect specific antibodies or to screen for ANAs, respectively. The antigens are either from cell extracts or recombinant. Blood serum is incubated in the wells of the plate and is washed out. If antibodies that bind to antigen are present then they will remain after washing. A secondary anti-human antibody conjugated to an enzyme such as horseradish peroxidase is added. The enzyme reaction will produce a change in colour of the solution that is proportional to the amount of antibody bound to the antigen.[11][54][64] There are significant differences in the detection of ANA by immunofluorescence and different ELISA kits and there is only a marginal agreement between these. A clinician must be familiar with the differences in order to evaluate the outcomes of the various assays.[63]
Sensitivity
The following table lists the sensitivity of different types of ANAs for different diseases.
| ANA type | Target antigen | Sensitivity (%) | ||||||
|---|---|---|---|---|---|---|---|---|
| SLE | Drug-induced LE | Diffuse systemic sclerosis | Limited systemic scleroderma | Sjögren syndrome | Inflammatory myopathy | MCTD | ||
| All ANAs (by indirect IF) |
Various | 95[65] | 100[65] | 80[65] | 80[65] | 70[65] | 40–60 | 95[65] |
| Anti-dsDNA | DNA | 60[65] | –[65] | –[65] | –[65] | 30[65] | – | -[65] |
| Anti-Sm | Core proteins of snRNPs | 40[65] | –[65] | –[65] | –[65] | –[65] | – | -[65] |
| Anti-histone | Histones | 60[65] | 90[65] | –[65] | –[65] | –[65] | – | -[65] |
| Anti Scl-70 | Type I topoisomerase | –[65] | –[65] | 20[65] | 10[65] | –[65] | – | -[65] |
| Anti-centromere | Centromeric proteins | –[65] | –[65] | 30[65] | 80[65] | –[65] | – | -[65] |
| SS-A (Ro) | RNPs | 40[65] | –[65] | –[65] | –[65] | 50[65] | 10 | -[65] |
| SS-B (La) | RNPs | 10–15 | – | – | – | 60–90 | – | |
| – = less than 5% sensitivity | ||||||||
Some ANAs appear in several types of disease, resulting in lower specificity of the test. For example, IgM-rheumatoid factor (IgM-RF) have been shown to cross-react with ANA giving falsely positive immunofluorescence.[66] Positive ANA as well as anti-DNA antibodies have been reported in patients with autoimmune thyroid disease.[67][68] ANA can have a positive test result in up to 45% of people with autoimmune thyroid conditions or rheumatoid arthritis and up to 15% of people with HIV or hepatitis C.[68][69][70][71] As per Lupus Foundation of America, "about 5% of the general population will have a positive ANA. However, at least 95% of the people who have a positive ANA do not have lupus. A positive ANA test can sometimes run in families, even if family members have no evidence of lupus."[10] On the other hand, they say, although 95% of the patients who actually have lupus test positive for ANA, "Only a small percentage have a negative ANA, and many of those have other antibodies (such as anti-phospholipid antibodies, anti-Ro, anti-SSA) or their ANA converted from positive to negative from steroids, cytotoxic medications, or uremia (kidney failure)."[10]
History
The LE cell was discovered in bone marrow in 1948 by Hargraves et al.[72] In 1957 Holborow et al. first demonstrated ANA using indirect immunofluorescence.[73] This was the first indication that processes affecting the cell nucleus were responsible for SLE. In 1959 it was discovered that serum from individuals with SLE contained antibodies that precipitated with saline extracts of nuclei, known as extractable nuclear antigens (ENAs). This led to the characterisation of ENA antigens and their respective antibodies. Thus, anti-Sm and anti-RNP antibodies were discovered in 1966 and 1971, respectively. In the 1970s, the anti-Ro/anti-SS-A and anti-La/anti-SS-B antibodies were discovered. The Scl-70 antibody was known to be a specific antibody to scleroderma in 1979, however the antigen (topoisomerase-I) was not characterised until 1986. The Jo-1 antigen and antibody were characterised in 1980.[8][20]
See also
References
- ^ Al-Mughales JA (2022). "Anti-Nuclear Antibodies Patterns in Patients With Systemic Lupus Erythematosus and Their Correlation With Other Diagnostic Immunological Parameters". Front Immunol. 13: 850759. doi:10.3389/fimmu.2022.850759. PMC 8964090. PMID 35359932.
Minor edits by Mikael Häggström, MD
- Attribution 4.0 International (CC BY 4.0) license - ^ "Medical Subject Headings (MeSH)". National Library of Medicine. Retrieved 12 February 2013.
- ^ a b Reece, Jane, Campbell, Neil (2005). Biology (7th ed.). San Francisco: Pearson/Benjamin-Cummings. ISBN 978-0805371468.
- ^ Cervera R, Font, J, Ramos-Casals, M, García-Carrasco, M, Rosas, J, Morlà, RM, Muñoz, FJ, Artigues, A, Pallarés, L, Ingelmo, M (2000). "Primary Sjögren's syndrome in men: clinical and immunological characteristics". Lupus. 9 (1): 61–4. doi:10.1177/096120330000900111. PMID 10713648. S2CID 39696993.
- ^ Barnett AJ, McNeilage, LJ (May 1993). "Antinuclear antibodies in patients with scleroderma (systemic sclerosis) and in their blood relatives and spouses". Annals of the Rheumatic Diseases. 52 (5): 365–8. doi:10.1136/ard.52.5.365. PMC 1005051. PMID 8323384.
- ^ Burdt MA, Hoffman, Robert W., Deutscher, Susan L., Wang, Grace S., Johnson, Jane C., Sharp, Gordon C. (1 May 1999). "Long-term outcome in mixed connective tissue disease: Longitudinal clinical and serologic findings". Arthritis & Rheumatism. 42 (5): 899–909. doi:10.1002/1529-0131(199905)42:5<899::AID-ANR8>3.0.CO;2-L. PMID 10323445.
- ^ Obermayer-Straub P, Strassburg, CP, Manns, MP (2000). "Autoimmune hepatitis". Journal of Hepatology. 32 (1 Suppl): 181–97. doi:10.1016/S0168-8278(00)80425-0. PMID 10728804.
- ^ a b c d e f g h i j Kavanaugh A, Tomar R, Reveille J, Solomon DH, Homburger HA (January 2000). "Guidelines for clinical use of the antinuclear antibody test and tests for specific autoantibodies to nuclear antigens. American College of Pathologists". Archives of Pathology & Laboratory Medicine. 124 (1): 71–81. doi:10.5858/2000-124-0071-GFCUOT. PMID 10629135.
- ^ Tan EM, Feltkamp, TE, Smolen, JS, Butcher, B, Dawkins, R, Fritzler, MJ, Gordon, T, Hardin, JA, Kalden, JR, Lahita, RG, Maini, RN, McDougal, JS, Rothfield, NF, Smeenk, RJ, Takasaki, Y, Wiik, A, Wilson, MR, Koziol, JA (September 1997). "Range of antinuclear antibodies in "healthy" individuals". Arthritis and Rheumatism. 40 (9): 1601–11. doi:10.1002/art.1780400909. PMID 9324014.
- ^ a b c "The Antinuclear Antibody Test: What It Means". Lupus Foundation of America. Retrieved 7 June 2013.
- ^ a b c d Kumar Y, Bhatia, A, Minz, RW (Jan 2, 2009). "Antinuclear antibodies and their detection methods in diagnosis of connective tissue diseases: a journey revisited". Diagnostic Pathology. 4: 1. doi:10.1186/1746-1596-4-1. PMC 2628865. PMID 19121207.
- ^ a b c d Yamamoto K (January 2003). "Pathogenesis of Sjögren's syndrome". Autoimmun Rev. 2 (1): 13–8. doi:10.1016/S1568-9972(02)00121-0. PMID 12848970.
- ^ Richardson B, Epstein, WV (September 1981). "Utility of the fluorescent antinuclear antibody test in a single patient". Annals of Internal Medicine. 95 (3): 333–8. doi:10.7326/0003-4819-95-3-333. PMID 7023311.
- ^ Malleson PN, Mackinnon MJ, Sailer-Hoeck M, Spencer CH (2010). "Review for the generalist: The antinuclear antibody test in children – When to use it and what to do with a positive titer". Pediatr Rheumatol Online J. 8: 27. doi:10.1186/1546-0096-8-27. PMC 2987328. PMID 20961429.
- ^ a b Damoiseaux JG, Tervaert, JW (January 2006). "From ANA to ENA: how to proceed?". Autoimmunity Reviews. 5 (1): 10–7. doi:10.1016/j.autrev.2005.05.007. PMID 16338206.
- ^ a b Wenzel J, Gerdsen, R, Uerlich, M, Bauer, R, Bieber, T, Boehm, I (December 2001). "Antibodies targeting extractable nuclear antigens: historical development and current knowledge". The British Journal of Dermatology. 145 (6): 859–67. doi:10.1046/j.1365-2133.2001.04577.x. PMID 11899137. S2CID 45350044.
- ^ a b Hernández-Molina G, Leal-Alegre, G, Michel-Peregrina, M (January 2011). "The meaning of anti-Ro and anti-La antibodies in primary Sjögren's syndrome". Autoimmunity Reviews. 10 (3): 123–5. doi:10.1016/j.autrev.2010.09.001. PMID 20833272.
- ^ Kassan SS, Moutsopoulos, HM (June 2004). "Clinical manifestations and early diagnosis of Sjögren syndrome". Arch Intern Med. 164 (12): 1275–84. doi:10.1001/archinte.164.12.1275. PMID 15226160.
- ^ Defendenti C, Atzeni, F, Spina, MF, Grosso, S, Cereda, A, Guercilena, G, Bollani, S, Saibeni, S, Puttini, PS (January 2011). "Clinical and laboratory aspects of Ro/SSA-52 autoantibodies". Autoimmunity Reviews. 10 (3): 150–4. doi:10.1016/j.autrev.2010.09.005. PMID 20854935.
- ^ a b c Venables PJ (June 2004). "Sjögren's syndrome". Best Practice & Research. Clinical Rheumatology. 18 (3): 313–29. doi:10.1016/j.berh.2004.02.010. PMID 15158743.
- ^ Clowse ME, Eudy AM, Kiernan E, Williams MR, Bermas B, Chakravarty E, Sammaritano LR, Chambers CD, Buyon J (1 July 2018). "The prevention, screening and treatment of congenital heart block from neonatal lupus: a survey of provider practices". Rheumatology. 57 (suppl_5): v9 – v17. doi:10.1093/rheumatology/key141. ISSN 1462-0332. PMC 6099126. PMID 30137589.
- ^ Sonesson SE, Hedlund M, Ambrosi A, Wahren-Herlenius M (1 October 2017). "Factors influencing fetal cardiac conduction in anti-Ro/SSA-positive pregnancies". Rheumatology. 56 (10): 1755–1762. doi:10.1093/rheumatology/kex263. ISSN 1462-0332. PMID 28957562. S2CID 3803597.
- ^ Scofield RH (May 8, 2004). "Autoantibodies as predictors of disease". Lancet. 363 (9420): 1544–6. doi:10.1016/S0140-6736(04)16154-0. PMID 15135604. S2CID 13983923.
- ^ Deshmukh US, Bagavant, H, Lewis, J, Gaskin, F, Fu, SM (November 2005). "Epitope spreading within lupus-associated ribonucleoprotein antigens". Clinical Immunology (Orlando, Fla.). 117 (2): 112–20. doi:10.1016/j.clim.2005.07.002. PMID 16095971.
- ^ Ben-Chetrit E (May 1993). "The molecular basis of the SSA/Ro antigens and the clinical significance of their autoantibodies". British Journal of Rheumatology. 32 (5): 396–402. doi:10.1093/rheumatology/32.5.396. PMID 8495261.
- ^ a b c d von Mühlen CA, Tan, EM (April 1995). "Autoantibodies in the diagnosis of systemic rheumatic diseases". Seminars in Arthritis and Rheumatism. 24 (5): 323–58. doi:10.1016/S0049-0172(95)80004-2. PMID 7604300.
- ^ Lyons R, Narain, S, Nichols, C, Satoh, M, Reeves, WH (June 2005). "Effective use of autoantibody tests in the diagnosis of systemic autoimmune disease". Annals of the New York Academy of Sciences. 1050 (1): 217–28. Bibcode:2005NYASA1050..217L. doi:10.1196/annals.1313.023. PMID 16014537. S2CID 7150107.
- ^ Zieve GW, Khusial, PR (September 2003). "The anti-Sm immune response in autoimmunity and cell biology". Autoimmunity Reviews. 2 (5): 235–40. doi:10.1016/S1568-9972(03)00018-1. PMID 12965173.
- ^ Migliorini P, Baldini, C, Rocchi, V, Bombardieri, S (February 2005). "Anti-Sm and anti-RNP antibodies". Autoimmunity. 38 (1): 47–54. doi:10.1080/08916930400022715. PMID 15804705. S2CID 1627719.
- ^ Benito-Garcia E, Schur, PH, Lahita, R, American College of Rheumatology Ad Hoc Committee on Immunologic Testing, Guidelines (Dec 15, 2004). "Guidelines for immunologic laboratory testing in the rheumatic diseases: anti-Sm and anti-RNP antibody tests". Arthritis and Rheumatism. 51 (6): 1030–44. doi:10.1002/art.20836. PMID 15593352.
- ^ Venables PJ (2006). "Mixed connective tissue disease". Lupus. 15 (3): 132–7. doi:10.1191/0961203306lu2283rr. PMID 16634365. S2CID 25736411.
- ^ Jimenez SA, Derk, CT (Jan 6, 2004). "Following the molecular pathways toward an understanding of the pathogenesis of systemic sclerosis". Annals of Internal Medicine. 140 (1): 37–50. doi:10.7326/0003-4819-140-2-200401200-00013. PMID 14706971.
- ^ a b c Ho KT, Reveille, JD (2003). "The clinical relevance of autoantibodies in scleroderma". Arthritis Research & Therapy. 5 (2): 80–93. doi:10.1186/ar628. PMC 165038. PMID 12718748.
- ^ Mahler M, Silverman ED, Schulte-Pelkum J, Fritzler MJ (September 2010). "Anti-Scl-70 (topo-I) antibodies in SLE: Myth or reality?". Autoimmun Rev. 9 (11): 756–60. doi:10.1016/j.autrev.2010.06.005. PMID 20601198.
- ^ Guldner HH, Szostecki, C, Vosberg, HP, Lakomek, HJ, Penner, E, Bautz, FA (1986). "Scl 70 autoantibodies from scleroderma patients recognize a 95 kDa protein identified as DNA topoisomerase I". Chromosoma. 94 (2): 132–8. doi:10.1007/BF00286991. PMID 2428564. S2CID 24851422.
- ^ Schmidt WA, Wetzel, W, Friedländer, R, Lange, R, Sörensen, HF, Lichey, HJ, Genth, E, Mierau, R, Gromnica-Ihle, E (2000). "Clinical and serological aspects of patients with anti-Jo-1 antibodies—an evolving spectrum of disease manifestations". Clinical Rheumatology. 19 (5): 371–7. doi:10.1007/s100670070030. PMID 11055826. S2CID 3014699.
- ^ Weinstein A, Bordwell, B, Stone, B, Tibbetts, C, Rothfield, NF (February 1983). "Antibodies to native DNA and serum complement (C3) levels. Application to diagnosis and classification of systemic lupus erythematosus". The American Journal of Medicine. 74 (2): 206–16. doi:10.1016/0002-9343(83)90613-7. PMID 6600582.
- ^ Mok CC, Lau, CS (July 2003). "Pathogenesis of systemic lupus erythematosus". Journal of Clinical Pathology. 56 (7): 481–90. doi:10.1136/jcp.56.7.481. PMC 1769989. PMID 12835292.
- ^ Yung S, Chan, TM (February 2008). "Anti-DNA antibodies in the pathogenesis of lupus nephritis—the emerging mechanisms". Autoimmunity Reviews. 7 (4): 317–21. doi:10.1016/j.autrev.2007.12.001. PMID 18295737.
- ^ Vasoo S (2006). "Drug-induced lupus: an update". Lupus. 15 (11): 757–61. doi:10.1177/0961203306070000. PMID 17153847. S2CID 17593016.
- ^ Katz U, Zandman-Goddard, G (November 2010). "Drug-induced lupus: an update". Autoimmunity Reviews. 10 (1): 46–50. doi:10.1016/j.autrev.2010.07.005. PMID 20656071.
- ^ Hu T, Guan, T, Gerace, L (August 1996). "Molecular and functional characterization of the p62 complex, an assembly of nuclear pore complex glycoproteins". The Journal of Cell Biology. 134 (3): 589–601. doi:10.1083/jcb.134.3.589. PMC 2120945. PMID 8707840.
- ^ Mackay IR, Whittingham, S, Fida, S, Myers, M, Ikuno, N, Gershwin, ME, Rowley, MJ (April 2000). "The peculiar autoimmunity of primary biliary cirrhosis". Immunological Reviews. 174: 226–37. doi:10.1034/j.1600-0528.2002.017410.x. PMID 10807519. S2CID 596338.
- ^ Kallenberg CG (March 1990). "Anti-centromere antibodies (ACA)". Clinical Rheumatology. 9 (1 Suppl 1): 136–9. doi:10.1007/BF02205562. PMID 2203592. S2CID 43833409.
- ^ Rattner JB, Mack, GJ, Fritzler, MJ (July 1998). "Autoantibodies to components of the mitotic apparatus". Molecular Biology Reports. 25 (3): 143–55. doi:10.1023/A:1016523013819. PMID 9700050. S2CID 8595680.
- ^ Renz H (2012). Autoimmune diagnostics. Berlin: De Gruyter. ISBN 978-3-11-022864-9.
- ^ JB Imboden, DB Hellmann, JH Stone. Current Rheumatology Diagnosis & Treatment, Second Edition. McGraw-Hill, 2007.
- ^ Nakamura M, Kondo H, Mori T, et al. (2007). "Anti-gp210 and anti-centromere antibodies are different risk factors for the progression of primary biliary cirrhosis". Hepatology. 45 (1): 118–27. doi:10.1002/hep.21472. PMID 17187436.
{{cite journal}}: CS1 maint: overridden setting (link) - ^ Worman HJ, Courvalin, JC (June 2003). "Antinuclear antibodies specific for primary biliary cirrhosis". Autoimmunity Reviews. 2 (4): 211–7. doi:10.1016/S1568-9972(03)00013-2. PMID 12848948.
- ^ Mahler M, Raijmakers, R (August 2007). "Novel aspects of autoantibodies to the PM/Scl complex: clinical, genetic and diagnostic insights". Autoimmunity Reviews. 6 (7): 432–7. doi:10.1016/j.autrev.2007.01.013. PMID 17643929.
- ^ Mahler M, Meroni PL, Andrade LE, Khamashta M, Bizzaro N, Casiano CA, Fritzler MJ (2016). "Towards a better understanding of the clinical association of anti-DFS70 autoantibodies". Autoimmunity Reviews. 15 (2): 198–201. doi:10.1016/j.autrev.2015.11.006. PMID 26588998.
- ^ Granito A, Muratori P, Quarneti C, Pappas G, Cicola R, Muratori L (January 2012). "Antinuclear antibodies as ancillary markers in primary biliary cirrhosis". Expert Review of Molecular Diagnostics. 12 (1): 65–74. doi:10.1586/erm.11.82. PMID 22133120. S2CID 28444340.
- ^ Klein WB (2000). Immunofluorescence in clinical immunology : a primer and atlas. Basel [u.a.]: Birkhäuser. ISBN 978-3764361822.
- ^ a b González-Buitrago JM, González, C (March 2006). "Present and future of the autoimmunity laboratory". Clinica Chimica Acta; International Journal of Clinical Chemistry. 365 (1–2): 50–7. doi:10.1016/j.cca.2005.07.023. PMID 16126186.
- ^ a b Tozzoli R, Bizzaro N, Tonutti E, Villalta D, Bassetti D, Manoni F, Piazza A, Pradella M, Rizzotti P (February 2002). "Guidelines for the laboratory use of autoantibody tests in the diagnosis and monitoring of autoimmune rheumatic diseases". American Journal of Clinical Pathology. 117 (2). Italian Society of Laboratory Medicine Study Group on the Diagnosis of Autoimmune Diseases: 316–24. doi:10.1309/Y5VF-C3DM-L8XV-U053. PMID 11863229.
- ^ a b Ulvestad E (March 2001). "Performance characteristics and clinical utility of a hybrid ELISA for detection of ANA". APMIS. 109 (3): 217–22. doi:10.1034/j.1600-0463.2001.090305.x. PMID 11430499. S2CID 22229427.
- ^ Lacroix M (January 2008). "Persistent use of "false" cell lines". Int. J. Cancer. 122 (1): 1–4. doi:10.1002/ijc.23233. PMID 17960586. S2CID 27432788.
- ^ Keren DF (June 2002). "Antinuclear antibody testing". Clinics in Laboratory Medicine. 22 (2): 447–74. doi:10.1016/S0272-2712(01)00012-9. PMID 12134471.
- ^ Nesher G, Margalit, R, Ashkenazi, YJ (April 2001). "Anti-nuclear envelope antibodies: Clinical associations". Seminars in Arthritis and Rheumatism. 30 (5): 313–20. doi:10.1053/sarh.2001.20266. PMID 11303304.
- ^ Sack U, Conrad, K, Csernok, E, Frank, I, Hiepe, F, Krieger, T, Kromminga, A, Landenberg, Pv, Messer, G, Witte, T, Mierau, R (June 2009). "Autoantibody detection by indirect immunofluorescence on HEp-2 cells" (PDF). Deutsche Medizinische Wochenschrift. 134 (24). die deutsche EASI-Gruppe (European Autoimmunity Standardization, Initiative): 1278–82. doi:10.1055/s-0029-1225278. PMID 19499499. S2CID 260097757.
- ^ Slater NG, Cameron, JS, Lessof, MH (September 1976). "The Crithidia luciliae kinetoplast immunofluorescence test in systemic lupus erythematosus". Clinical and Experimental Immunology. 25 (3): 480–6. PMC 1541410. PMID 786521.
- ^ Shapiro TA, Englund PT (1995). "The structure and replication of kinetoplast DNA". Annual Review of Microbiology. 49: 117–43. doi:10.1146/annurev.mi.49.100195.001001. PMID 8561456.
- ^ a b Emlen W, O'Neill, L (September 1997). "Clinical significance of antinuclear antibodies: comparison of detection with immunofluorescence and enzyme-linked immunosorbent assays". Arthritis and Rheumatism. 40 (9): 1612–8. doi:10.1002/art.1780400910. PMID 9324015.
- ^ Deshpande, S. S. (1996). Enzyme immunoassays: from concept to product development. London: Chapman & Hall. ISBN 978-0-412-05601-7.
- ^ a b c d e f g h i j k l m n o p q r s t u v w x y z aa ab ac ad ae af ag ah ai aj ak al am an ao ap Table 6-2 in: Elizabeth D Agabegi, Agabegi, Steven S. (2008). Step-Up to Medicine (Step-Up Series). Hagerstwon, MD: Lippincott Williams & Wilkins. ISBN 978-0-7817-7153-5.
- ^ Frokjaer VG, Mortensen, Erik L., Nielsen, Finn Å., Haugbol, Steven, Pinborg, Lars H., Adams, Karen H., Svarer, Claus, Hasselbalch, Steen G., Holm, Soeren, Paulson, Olaf B., Knudsen, Gitte M. (29 February 2008). "Frontolimbic Serotonin 2A Receptor Binding in Healthy Subjects Is Associated with Personality Risk Factors for Affective Disorder". Biological Psychiatry. 63 (6): 569–576. doi:10.1016/j.biopsych.2007.07.009. PMID 17884017. S2CID 25979780.
- ^ Tektonidou MG, Anapliotou M, Vlachoyiannopoulos P, Moutsopoulos HM (1 September 2004). "Presence of systemic autoimmune disorders in patients with autoimmune thyroid diseases". Annals of the Rheumatic Diseases. 63 (9): 1159–1161. doi:10.1136/ard.2004.022624. PMC 1755126. PMID 15308528.
- ^ a b Petri M, Karlson, EW, Cooper, DS, Ladenson, PW (October 1991). "Autoantibody tests in autoimmune thyroid disease: a case-control study". The Journal of Rheumatology. 18 (10): 1529–31. PMID 1765977.
- ^ Charles PJ, Smeenk, R. J. T., De Jong, J., Feldmann, M., Maini, R. N. (1 November 2000). "Assessment of antibodies to double-stranded DNA induced in rheumatoid arthritis patients following treatment with infliximab, a monoclonal antibody to tumor necrosis factor α: Findings in open-label and randomized placebo-controlled trials". Arthritis & Rheumatism. 43 (11): 2383–2390. doi:10.1002/1529-0131(200011)43:11<2383::AID-ANR2>3.0.CO;2-D. PMID 11083258.
- ^ Cassani F, Cataleta, M, Valentini, P, Muratori, P, Giostra, F, Francesconi, R, Muratori, L, Lenzi, M, Bianchi, G, Zauli, D, Bianchi, F B (1 September 1997). "Serum autoantibodies in chronic hepatitis C: Comparison with autoimmune hepatitis and impact on the disease profile". Hepatology. 26 (3): 561–566. doi:10.1002/hep.510260305. PMID 9303483. S2CID 3228360.
- ^ Medina-Rodriguez F, Guzman, C, Jara, LJ, Hermida, C, Alboukrek, D, Cervera, H, Miranda, JM, Fraga, A (November 1993). "Rheumatic manifestations in human immunodeficiency virus positive and negative individuals: a study of 2 populations with similar risk factors". The Journal of Rheumatology. 20 (11): 1880–4. PMID 8308773.
- ^ Hargraves M, Richmond H, Morton R. Presentation of two bone marrow components, the tart cell and the LE cell. Mayo Clin Proc 1948;27:25–28.
- ^ Holborow EJ, Weir, D. M., Johnson, G. D. (28 September 1957). "A Serum Factor in Lupus Erythematosus with Affinity for Tissue Nuclei". BMJ. 2 (5047): 732–734. doi:10.1136/bmj.2.5047.732. PMC 1962253. PMID 13460368.
External links
- Autoimmunityblog – HEp-2 ANA summary
- Antinuclear+antibodies at the U.S. National Library of Medicine Medical Subject Headings (MeSH)
- Greidinger EL, Hoffman, DO, Robert W. (31 January 2003). "CE update [chemistry | immunology]: Antinuclear Antibody Testing: Methods, Indications, and Interpretation". Laboratory Medicine. 34 (2): 113–117. doi:10.1309/VUB90VTPMEWV3W0F.